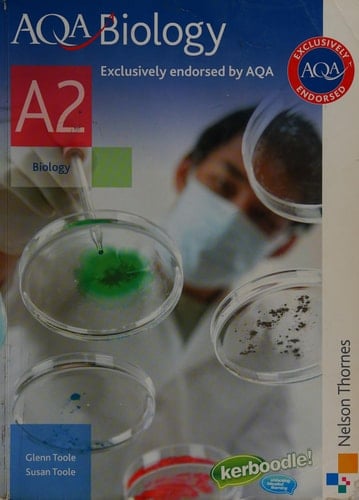
AQA Biology A2

Author Description
This book covers everything you need for the AQA Biology AS specification, including the skills required for How Science Works and practical assessment. Learning Objectives clearly referenced to the specification throughout tell you exactly what you need to learn and understand in each topic. Includes activities to practice investigative skills with detailed notes on practical experiments. Extension materials also provide extra challenges, helping to develop key skills.
Page Count:
328
Publication Date:
2008-11-21
ISBN-10:
0748798137
ISBN-13:
9780748798131
Community Tags
Reader Comments
Share Your Thoughts
No comments yet. Be the first to share your thoughts!